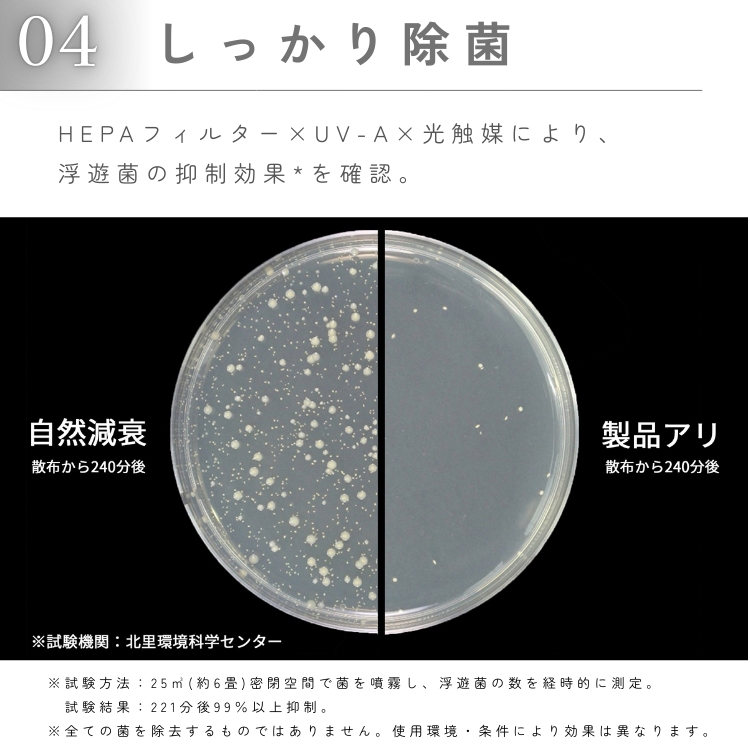

| 商品名 | UZUKAZE 3 |
|---|---|
| カラー | ホワイト |
| サイズ | 幅530mm x 奥行き530mm x 高さ100mm |
| 重量 | 3.7kg |
| 素材 | 樹脂・スチール |
| 機能 | 調光調色機能、空気循環(6段階)、UV-A/光触媒、Matter対応、リモコン付 |
| 仕様 | 消費電力(最大):58W 器具光束:5500lm 定格寿命:40,000h 色温度:3,000K〜6,500K Ra:80 消費効率:131lm/w |
| 注意事項 | ※商品の色はモニターの具合で実物と若干異なる場合がございます。 |
| メーカー/ブランド | スワン電器 |
| 区分 | 家電 |
| 広告文責 | 株式会社プロデュース/080-6266-0466 |
| 製造国 | 中国 |